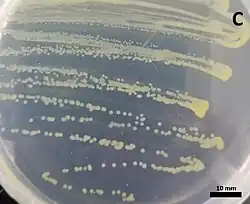

Massilia dura
| Massilia dura | ||
|---|---|---|
![]() | ||
| Taxonomía | ||
| Dominio: | Bacteria | |
| Reino: | Pseudomonadati | |
| Filo: | Pseudomonadota | |
| Clase: | Betaproteobacteria | |
| Orden: | Burkholderiales | |
| Familia: | Oxalobacteraceae | |
| Género: | Massilia | |
| Especie: |
Massilia dura Zhang et al. 2006 | |
Massilia dura es una bacteria gramnegativa del género Massilia. Fue descrita en el año 2006. Su etimología hace referencia a dura.[1] Es aerobia y móvil por uno o más flagelos. Tiene un tamaño de 0,7-0,8 μm de ancho por 2-2,5 μm de largo. Forma colonias circulares, convexas, opacas, duras, compactas y de color entre blanco y amarillo. Temperatura de crecimiento entre 10-45 °C, óptima de 28-30 °C. Catalasa y oxidasa positivas. Tiene un contenido de G+C de 65,9%. Se ha aislado de suelos contaminados con metales pesados en Nankín, China.[2]
Referencias
- ↑ Zhang, Yu-Qin; Li, Wen-Jun; Zhang, Ke-Yun; Tian, Xin-Peng; Jiang, Yi; Xu, Li-Hua; Jiang, Cheng-Lin; Lai, Ren (2006-02). «Massilia dura sp. nov., Massilia albidiflava sp. nov., Massilia plicata sp. nov. and Massilia lutea sp. nov., isolated from soils in China». International Journal of Systematic and Evolutionary Microbiology 56 (Pt 2): 459-463. ISSN 1466-5026. PMID 16449458. doi:10.1099/ijs.0.64083-0. Consultado el 4 de febrero de 2023.
- ↑ «Leibniz Institute DSMZ: Details». www.dsmz.de. Consultado el 25 de abril de 2025.
